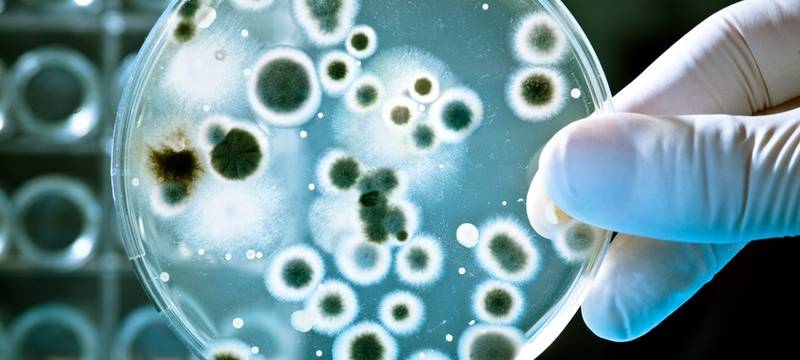
Kreuzfahrtschiff-Passagiere doch nicht in Quarantäne

© Alexander Raths - Fotolia
© Alexander Raths - Fotolia
Kreuzfahrtschiff-Passagiere doch nicht in Quarantäne
Vier Kreuzfahrtpassagiere aus Dorsten und Recklinghausen, die wegen des Corona-Virus in Kambodscha festsaßen, müssen doch nicht in häusliche Quarantäne.
Veröffentlicht: Freitag, 21.02.2020 12:48
Anzeige
Kurz nach dem sie heute Morgen zurück ins Vest kamen, wurde ihre Warnstufe heruntergesetzt. Das heißt: Sie dürfen ihre Wohnung verlassen. Ihnen wird aber zum Beispiel empfohlen, nicht auf Großveranstaltungen zu gehen. Das gilt erst einmal für eine Woche. Sollten sie sich in dieser Zeit plötzlich doch krank fühlen, ist das Kreisgesundheitsamt in ständiger Rufbereitschaft. Auf dem Schiff war ein Passagier positiv auf das Corona-Virus getestet worden, alle anderen Tests waren negativ.
Anzeige